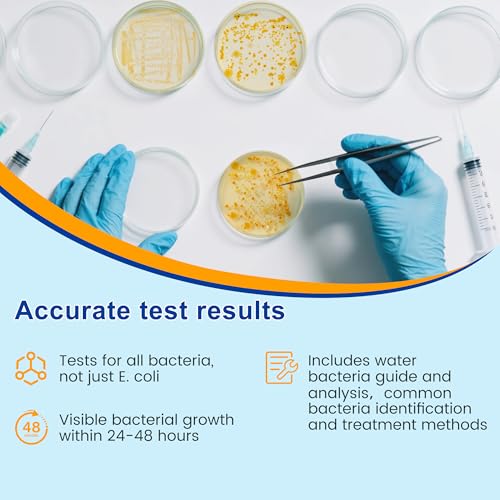
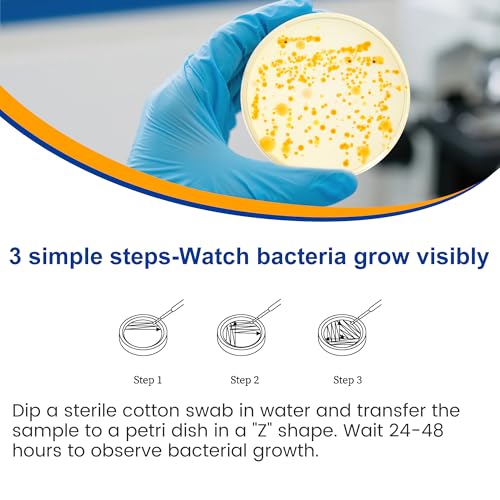

Kits de prueba de bacterias para agua potable – 12 pruebas detectan coliformes, E.coli y todas las bacterias | Kit de prueba de calidad del hogar para agua de pozo, grifo, piscina, bañera de
【Kit Completo de Prueba de Agua】- El Kit de Prueba de Bacterias Funhaosta incluye 12 placas de cultivo, instrucciones detalladas de prueba, una guía de identificación bacteriana con recomendaciones de tratamiento, 12 hisopos estériles, etiquetas adhesivas, guantes de prueba y bolsas sellables. Todo está incluido – no requiere suministros adicionales!
【Resultados de prueba precisos】- A diferencia de las tiras de prueba que cambian de color, nuestro kit le permite observar visualmente el crecimiento bacteriano en las placas de cultivo en un plazo de 24 a 48 horas, proporcionando resultados más confiables y verificables.
Prueba universal de agua: prueba de forma segura todas las fuentes de agua, incluyendo agua del grifo, agua de pozo, agua de piscina, acuarios y mucho más. Perfecto para hogares, caravanas, viajes de campamento y uso al aire libre para garantizar que tu agua esté libre de bacterias.
Amazon.com Price: El precio original era: 25,89 €.24,17 €El precio actual es: 24,17 €. IVA incluido (as of 12/03/2026 06:17 PST- Details)
【Equipment Completo de Prueba de Agua】- El Equipment de Prueba de Bacterias Funhaosta incluye 12 placas de cultivo, instrucciones detalladas de prueba, una guía de identificación bacteriana con recomendaciones de tratamiento, 12 hisopos estériles, etiquetas adhesivas, guantes de prueba y bolsas sellables. Todo está incluido – no requiere suministros adicionales!
【Resultados de prueba precisos】- A diferencia de las tiras de prueba que cambian de colour, nuestro Equipment le permite observar visualmente el crecimiento bacteriano en las placas de cultivo en un plazo de 24 a 48 horas, proporcionando resultados más confiables y verificables.
Prueba common de agua: prueba de forma segura todas las fuentes de agua, incluyendo agua del grifo, agua de pozo, agua de piscina, acuarios y mucho más. Perfecto para hogares, caravanas, viajes de campamento y uso al aire libre para garantizar que tu agua esté libre de bacterias.
【Detecta TODAS las Bacterias】- Pruebas exhaustivas para l. a. contaminación bacteriana general, no solo E.coli/coliformes. Identifica bacterias dañinas como Salmonella, Staphylococcus aureus, Pseudomonas aeruginosa y otras bacterias comunes transmitidas por el agua.
Análisis experto gratuito: ¿no puedes identificar las bacterias? Simplemente envíenos fotos claras de sus placas de cultivo para un análisis profesional. No es necesario enviar muestras por correo: ¡proporcionaremos un informe detallado de análisis de bacterias!
Garantía de seguridad en el agua: el Equipment de pruebas profesional de Funhaosta te da tranquilidad al garantizar l. a. seguridad del agua de tu familia. Nuestro completo sistema de detección bacteriana ayuda a prevenir enfermedades transmitidas por el agua, protegiendo lo que más importa: tu salud y tus seres queridos.